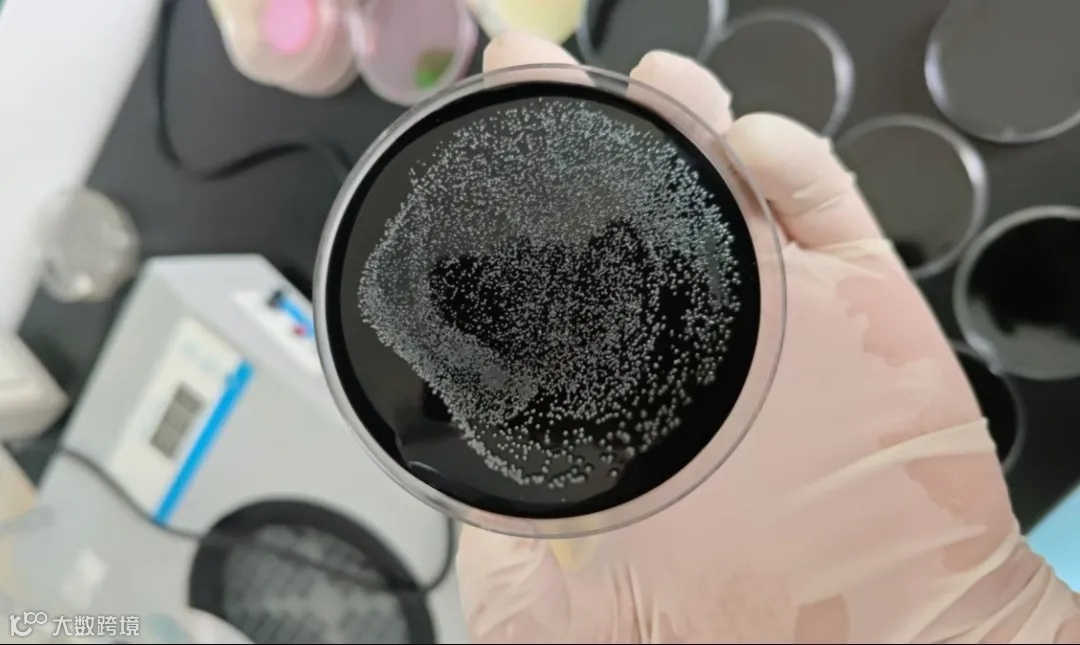

有这样一群人
他们在工作中
精进技术 提升技能
敢于挑战 积极突破
让我们一起去看看吧

青港物流叉车司机山长峰不断提升对叉车吊具、手柄控制以及空间距离的预判能力和定位水平,夯实机械操作平稳、快捷的基本功,练就“平台取球”操作绝活,让庞大的叉车如臂指使、灵活作业。
鲁检检测实验室的检测员们通过选择合适的培养基和培养温度,把进口船舶、货物上的微生物筛选出来,科学评判消杀效果,全面筑牢国门安全屏障。

在日照区域公司“散改集”全自动工艺系统生产现场,操作员手持遥控器,8分钟内完成一台半挂车的卸车作业,大幅度减少司机的在港停时。

面对件杂货班轮密集抵港,烟台区域公司件杂货业务团队全程跟踪作业现场,做好流程衔接,确保船舶高效通关、鸣笛启程。

在跨境电商监管场所放行流水线上,威海物流园电商经营中心理货员认真做好2000余单进口包裹通关工作,全面畅通跨境电商进口通道。

在日照区域公司场站操作中心,轨道吊司机高效做好海铁联运班列装卸工作,并利用停机时间,对轨道吊进行“把脉问诊”,保证其健康运行。
每一次“拿捏”
背后都是山港物流人
智慧与汗水的凝聚
让我们继续努力
继续“拿捏”!
来源:山东港口物流集团

